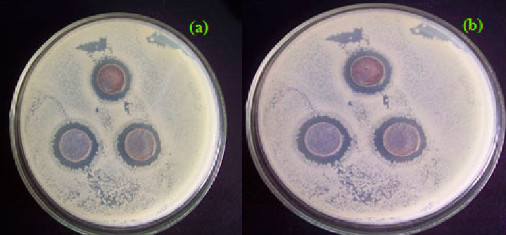
5.png

3月21日,全球钛产业峰会暨涂多多2019钛产业互联网发展论坛在京召开。河北麦森钛白粉有限公司技术中心主任 张千先生为与会企业带来“纳米二氧化钛在功能性涂料中的应用”的主题分享,以下为演讲速记……
——————————————————————————————————
各位同仁大家好,我非常感谢2019年千人峰会给我这个机会,能够代表河北麦森钛白粉有限公司分享一下我司纳米二氧化钛在功能性涂料中研究进展。
首先先介绍一下河北麦森,成立于2007年,坐落于河北鹿泉,是一家集纳米二氧化钛功能性纳米新材料的研发、中试、生产于一体的科技型创新企业。公司始终坚持着科技创新、技术导向的经营理念,努力开展新产品的研制以及拓展产品应用市场。目前产品分为三大系列31种,这个是我们的荣誉,公司属于高新技术企业。麦森研发投入还是很高的,研发团队有30多人,有博士、硕士和学士组成。目前申报的专利80多项,授权的40多项,刊物发表论文40余篇。
今天和大家分享一下纳米二氧化钛光催化机理,第二就是影响二氧化钛光催化性能因素,第三在功能性涂料中的应用,最后是展望和对未来的期许。
大家会问什么是纳米?任何的氧化物小于100个纳米都统称为纳米氧化物。现在是世界上使用比较广泛的光催化新材料。纳米二氧化钛是一种N型的半导体材料,但是由于不连续性,它的催化作用和它的能带的结构有关系。什么叫能带,这个就是它的能带,下面灰色线条是已经充满了电子的低能带,上面是高能带,是空的,叫做导带,在导带和价带之间的叫禁带,并不是所有波段的光都可以被二氧化钛吸收形成催化反应,只有这个光子能量大于禁带宽度时才能被二氧化钛吸收,产生催化反应。

大家可以看下这个图,上面这个UV是它的光子能大于禁带宽度的,他可以使用,激发二氧化钛,在二氧化钛的价带会产生光电子,在价带形成一个电子空穴,同时形成光电子空穴对。生成超氧自由基,和氢离子反应会形成羟基自由基,空穴可以和水和羟基反应形成羟基自由基,这个是可以和有机物形成反应,降解为二氧化钛和水。

这个图是比较简单的图,这是属于重点,首先在紫外线C波段激发二氧化钛形成电子跃迁,形成电子空穴对,跟水反应形成羟基自由基,羟基自由基分解有机物,形成比较净化的空气。在这个反应过程中,形成重新复合,会有热能的释放。
影响二氧化钛光催化性能的因素。
如果二氧化钛达到纳米级会产生四种效应:第一,量子效应,相当于是最基本的光催化反应所能发生的根本,随着吸收的光谱可以向短波迁移,同时扩大对太阳可利用的波段。减少光生电子空穴的复合,产生的电子空穴电子存在比较狭小的空间,它的复合机率比较高,让光电子和氧气水发生反应,这个催化才能完成。可以提高光催化效率。随着粒径的降低、减小,它会增加比表面积,随着比表面积增加,比表面积越大对于水、氧气以及有机废物的吸附能力更加强,它变相地增加了接触和反应的机率,提高它的催化效率。
第二,针对纳米二氧化钛的掺杂和改性。点子空穴对具有更正或者更负的电位,氧化能力。增强表面吸附水和羟基能力,有利于对氧气的化学吸附。
第三,掺杂能级,增大载流子扩散长度,延长电子和空穴寿命,高效地利用已经吸收的光能,提高二氧化钛的光催化活性。对于表面羟基化的影响。羟基为活性位点,是氧气和有机物主要吸附位。如果它数量增多的话,肯定光催化效率也会提高。
第四,其他一些因素,包括我们对产品的配方设计,包括纳米的二氧化钛的用量,当然用量更多肯定它的效率更高。还有污染物的浓度,在高浓度区、中浓度区、低浓度区对于实际达到效果还是有很大的影响。还有体系PH值,它的分散情况和适用情况都是受PH值影响的。还有就是光源强度,这个对效率也是有很大的影响。
第二点中,纳米二氧化钛在功能性涂料中的应用,装修用的建材会释放很多有害气体,还有汽车的尾气,都是这些因素造成的。我们公司针对这些需求对他的粒径和掺杂做了一些改变,能够更适应这些功能。
这个空气污染物无处不在,目前有两种纳米二氧化钛空气净化涂料的涂覆方式,第一是室外,涂在建筑外层,能够净化空气中的氮氧化物,以及空气中游离的废物。再一个就是室内,喷到表面,比如说地毯、窗帘等等。

图4是不同时间纳米二氧化钛紫外光催化甲醛降解率。图6是我们公司的产品跟国际上目前有的两款产品作出同等环境下的对比实验,最上面黑色是我们产品,还是有优越性的。
抗菌杀菌涂料,纳米二氧化钛是无毒无害的,是非常清洁的,而现在所用的杀菌剂它不是那么环保,这一点是他的优越性,具体的反应机理有两种,第一种是直接反应,在紫外线照射下利用光电子以及光电子空穴直接对细胞膜和细胞壁进行化学反应,杀死细菌。第二、间接的,紫外线照射后形成自由基,再跟细胞膜和细胞壁产生化学反应。图7是用纳米二氧化钛做的一个抗菌持久性的测试,它针对的菌种是枯草芽孢芽孢杆菌,它的抑菌是比较有持续性的。
自清洁涂料,自然界中有很多是具有自清洁功能的。我们公司参照疏水性特性研发的这款产品,也是对它进行了掺杂改性。
原理两种:一、通过紫外线照射,让二氧化钛形成催化反应,从而形成羟基自由基,它可以分解附着在涂料表面上的这些有机物,从而形成自清洁。第二种、在光照之下它可以转化为双亲表面,使污染物能与表面更紧密的结合,能够提高它的降解效率,同时可以提高雨水的冲刷对它表面进行自清洁。
防污涂料,主要也是涂装于船底和海洋水下设施。它主要优越处就是环保,它代替了传统防污涂中添加的重金属和有毒物质。而纳米二氧化钛是无毒无害的。由于二氧化钛具有极高的表面能和很强的疏水作用,微生物很难在表面上生长或者粘附,所以具有很好的防污效果。
其实对于纳米材料研究做了很多年了,广义地来讲,可以这样说,大部分氧化物一旦它的粒径达到纳米级别的话,它的特性就可以展现出来,这只是开发了很小一部分,还有很大一部分空间可以开发的。而且纳米材料是针对与现有的一些材料,它的好处就是环保性,而且更高效、更持久的反映。我也是非常期待更多人对纳米氧化物产生兴趣,可以挖掘出更多纳米氧化物的功能,非常感谢大家!